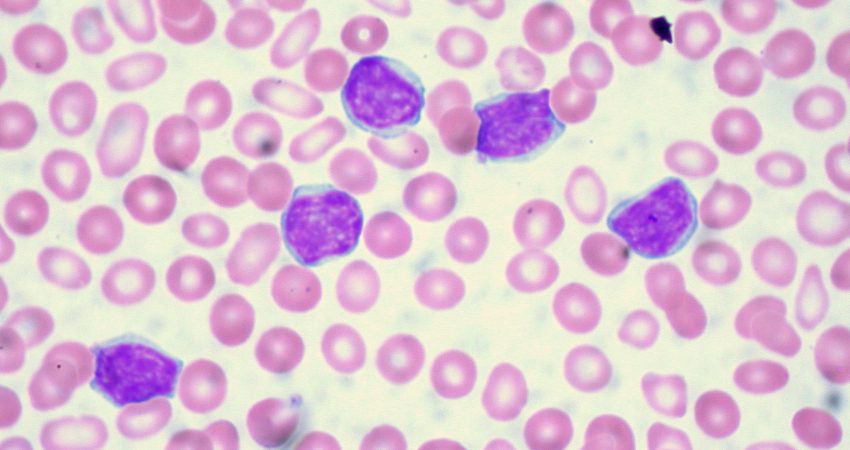

Shumica e njerëzve përjetojnë djersitje natën në një moment të jetës së tyre. Kjo ndodh për shkak të ngrohtësisë së dhomës së gjumit, përdorimi i shumë batanijeve ose përjetimi i ndryshimeve hormonale. Këto janë vetëm disa nga shumë gjëra që mund t’ju bëjnë të djersiteni gjatë gjumit. Por nëse jeni duke përjetuar djersitje të vazhdueshme gjatë natës, duhet të konsultoheni me mjekun tuaj, pasi djersitjet e natës të kësaj natyre janë një shenjë e llojeve të caktuara të kancerit, duke përfshirë leuçeminë limfocitare kronike (CLL).
Në këtë lloj leuçemie, qelizat e kancerit janë shumë të ngjashme me qelizat normale të quajtura prolimfocite. KËto qeliza priren të rriten dhe të përhapen më shpejt se lloji i zakonshëm i CLL. Shumica e njerëzve me të do t’i përgjigjen një forme trajtimi, por me kalimin e kohës ata janë të prirur për përsëritje të kancerit.
Ekspertë kanë konstatuar se ekzistojnë 2 lloje të ndryshme të CLL. Një lloj që rritet shumë ngadalë. Pra, mund të duhet një kohë e gjatë para se pacienti të ketë nevojë për trajtim dhe lloji tjetër që rritet më shpejt dhe është një sëmundje më serioze.

Qelizat e leukemisë nga këto 2 lloje duken njësoj, por testet laboratorike mund të tregojnë dallimin mes tyre. Nëse qelizat CLL kanë sasi të ulëta të këtyre proteinave, leuçemia priret të rritet më ngadalë dhe të ketë rezultate më të mira afatgjata.
Çfarë e shkakton lidhjen mes djersitjeve dhe leuçemisë limfocitare kronike?
Leuçemia kronike limfocitare është një kancer që shfaqet në një lloj qelize të bardhë të gjakut të quajtur limfocitet. Ky kancer rritet ngadaltë dhe shumë njerëz nuk kanë simptoma në kohën e diagnozës. Në vend të kësaj, shpesh zbulohet kur ka një anomali të qelizave të bardha të gjakut gjatë kontrrollit rutinë.
Megjithatë, në disa raste, djersitjet e natës mund të shfaqen si simptomë edhe para se të vendoset diagnoza e CLL. Shkaku i saktë i djersitjes gjatë natës është i panjohur, por besohet se trupi juaj mund të rrisë temperaturën e tij si pjesë e një reagimi inflamator për të provuar dhe “luftuar” qelizat e kancerit. Nëse djersitjet tuaja gjatë natës kanë zgjatur për disa javë, mjeku juaj duhet t’ju këshillojë të bëni disa testime të mëtejshme, veçanërisht nëse simptoma të tjera të leuçemisë, të tilla si humbja e peshës, lodhja, mavijosje, nyjet limfatike të zmadhuara dhe zmadhimi i shpretkës.
CLL gjithashtu mund të dobësojë sistemin tuaj imunitar dhe t’ju bëjë më të prirur ndaj infeksioneve. Si rezultat, mund të përjetoni ethe dhe djersitje gjatë natës si rezultat i reagimit të trupit tuaj kundër një infeksioni. Edhe pas një diagnoze të CLL, djersitjet e përkeqësuara gjatë natës mund të jenë një shenjë që kanceri juaj po përparon, duke treguar se mund të jetë koha për të filluar trajtimin.
Burimi:CNN/Përshtati:Gazeta “Si”
Copyright © Gazeta “Si”
Të gjitha të drejtat e këtij materiali janë pronë ekskluzive dhe e patjetërsueshme e Gazetës “Si”, sipas Ligjit Nr.35/2016 “Për të drejtat e autorit dhe të drejtat e tjera të lidhura me to”. Ndalohet kategorikisht kopjimi, publikimi, shpërndarja, tjetërsimi etj, pa autorizimin e Gazetës “Si”, në të kundërt çdo shkelës do mbajë përgjegjësi sipas nenit 179 të Ligjit 35/2016.
.png)

Lini një Përgjigje